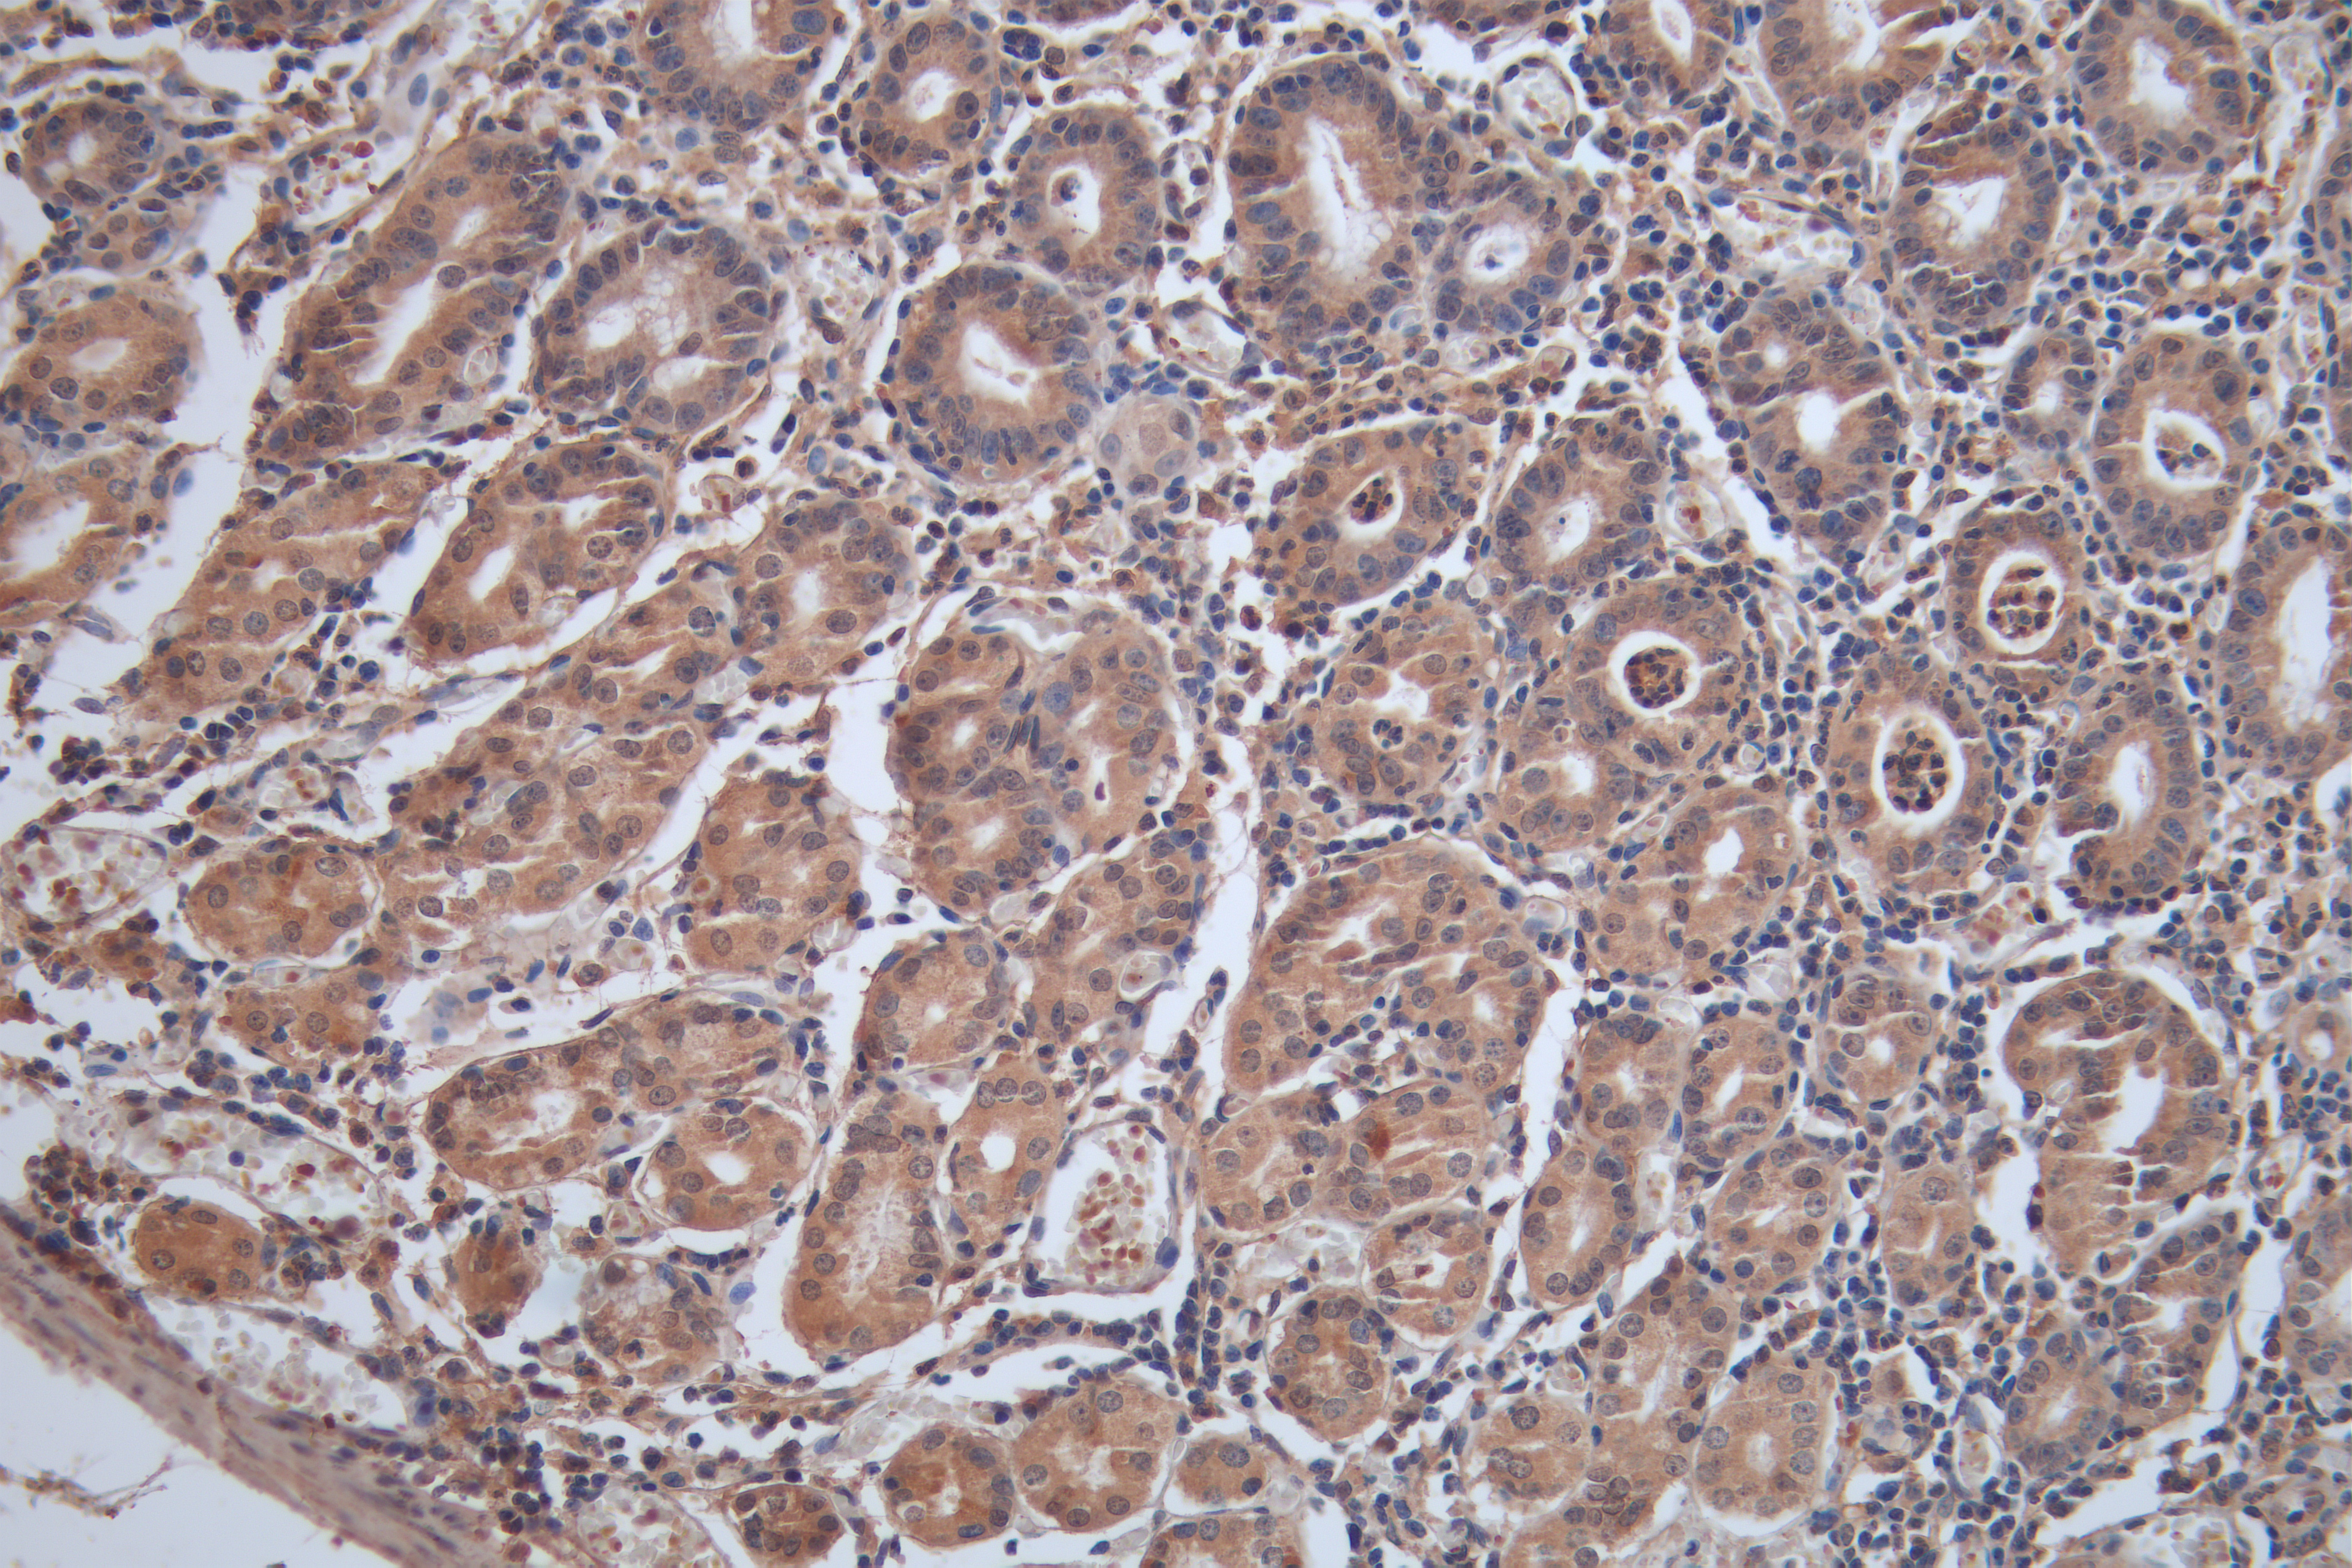

-
中文名稱:MT1G兔多克隆抗體
-
貨號:CSB-PA17384A0Rb
-
規格:¥440
-
圖片:
-
IHC image of CSB-PA17384A0Rb diluted at 1:100 and staining in paraffin-embedded human liver tissue performed on a Leica BondTM system. After dewaxing and hydration, antigen retrieval was mediated by high pressure in a citrate buffer (pH 6.0). Section was blocked with 10% normal goat serum 30min at RT. Then primary antibody (1% BSA) was incubated at 4°C overnight. The primary is detected by a Goat anti-rabbit polymer IgG labeled by HRP and visualized using 0.05% DAB.
-
IHC image of CSB-PA17384A0Rb diluted at 1:100 and staining in paraffin-embedded human liver cancer performed on a Leica BondTM system. After dewaxing and hydration, antigen retrieval was mediated by high pressure in a citrate buffer (pH 6.0). Section was blocked with 10% normal goat serum 30min at RT. Then primary antibody (1% BSA) was incubated at 4°C overnight. The primary is detected by a Goat anti-rabbit polymer IgG labeled by HRP and visualized using 0.05% DAB.
-
IHC image of CSB-PA17384A0Rb diluted at 1:100 and staining in paraffin-embedded human stomach tissue performed on a Leica BondTM system. After dewaxing and hydration, antigen retrieval was mediated by high pressure in a citrate buffer (pH 6.0). Section was blocked with 10% normal goat serum 30min at RT. Then primary antibody (1% BSA) was incubated at 4°C overnight. The primary is detected by a Goat anti-rabbit polymer IgG labeled by HRP and visualized using 0.05% DAB.
-
Measured by its binding ability in a functional ELISA.Immobilized Human MT1G(CSB-RP173844h) at 2 μg/mL can bind anti-MT1G antibody(CSB-PA17384A0Rb).
-
-
其他:
產品詳情
-
產品描述:
CUSABIO produced the MT1G polyclonal antibody (CSB-PA17384A0Rb) by immunizing rabbits with the synthetic peptide corresponding to the amino acids 1-59 of the recombinant human MT1G protein. The anti-MT1G antibody was purified from rabbit antiserum by protein G affinity chromatography. Its purity reaches up to 95%. It occurs as an unconjugated IgG.
This MT1G polyclonal antibody only reacts with human MT1G, which suppresses growth, migration, and invasion but induces cell cycle arrest and apoptosis in thyroid cancer cells. This MT1G antibody is suitable for the detection of MT1G protein in ELISA and IHC applications.
-
產品名稱:Rabbit anti-Homo sapiens (Human) MT1G Polyclonal antibody
-
Uniprot No.:
-
基因名:MT1G
-
別名:Metallothionein-1G antibody; Metallothionein-1K antibody; Metallothionein-IG antibody; MT-1G antibody; MT-1K antibody; MT-IG antibody; MT1G antibody; MT1G_HUMAN antibody
-
宿主:Rabbit
-
反應種屬:Human
-
免疫原:Recombinant Human Metallothionein-1G protein (1-59AA)
-
免疫原種屬:Homo sapiens (Human)
-
標記方式:Non-conjugated
本頁面中的產品,MT1G Antibody (CSB-PA17384A0Rb),的標記方式是Non-conjugated。對于MT1G Antibody,我們還提供其他標記。見下表:
-
克隆類型:Polyclonal
-
抗體亞型:IgG
-
純化方式:>95%, Protein G purified
-
濃度:It differs from different batches. Please contact us to confirm it.
-
保存緩沖液:Preservative: 0.03% Proclin 300
Constituents: 50% Glycerol, 0.01M PBS, PH 7.4 -
產品提供形式:Liquid
-
應用范圍:ELISA, IHC
-
推薦稀釋比:
Application Recommended Dilution IHC 1:20-1:200 -
Protocols:
-
儲存條件:Upon receipt, store at -20°C or -80°C. Avoid repeated freeze.
-
貨期:Basically, we can dispatch the products out in 1-3 working days after receiving your orders. Delivery time maybe differs from different purchasing way or location, please kindly consult your local distributors for specific delivery time.
-
用途:For Research Use Only. Not for use in diagnostic or therapeutic procedures.
引用文獻
- Viral-Track integrated single-cell RNA-sequencing reveals HBV lymphotropism and immunosuppressive microenvironment in HBV-associated hepatocellular carcinoma Z Liu, W Naz, T Yousaf, J Sun, Q Wu, M Guo,Communications Biology,2025
- Ferroptosis‐Related Genes Are Effective Markers for Diagnostic Targets of Crohn's Disease P Liu, Q Liu, Y Tian, P Cai, J Bai,Immunity, Inflammation and Disease,2025
- MT1G induces lipid droplet accumulation through modulation of H3K14 trimethylation accelerating clear cell renal cell carcinoma progression S Wang,British journal of cancer,2024
- Extracellular vesicles activated cancer-associated fibroblasts promote lung cancer metastasis through mitophagy and mtDNA transfer Z Zhou,Journal of experimental & clinical cancer research,2024
- MT1G, an emerging ferroptosis‐related gene: A novel prognostic biomarker and indicator of immunotherapy sensitivity in prostate cancer B Cheng,Environmental toxicology,2023
相關產品
靶點詳情
-
功能:Metallothioneins have a high content of cysteine residues that bind various heavy metals; these proteins are transcriptionally regulated by both heavy metals and glucocorticoids.
-
基因功能參考文獻:
- These findings indicate that MT1 constitute a biomarker adapted for exploring the impact of sorafenib on the redox metabolism of cancer cells. PMID: 27184800
- A new tumor-suppressor activity of MT1G in colorectal cancer cells.MT1G role in cell differentiation. PMID: 28393194
- PU.1 suppressive target gene, metallothionein 1G, inhibits retinoic acid-induced NB4 cell differentiation PMID: 25072246
- MT1G was down-regulated in renal cell carcinogenesis. PMID: 24662736
- MT1M and MT1G promoter methylation may be used as serum biomarkers for noninvasive detection of hepatocellular carcinoma. PMID: 24782625
- Metallothionein 1G and zinc sensitize human colorectal cancer cells to chemotherapy. PMID: 24634414
- Metallothionein 1G functions as a tumor suppressor in thyroid cancer through modulating the PI3K/Akt signaling pathway. PMID: 24098937
- GPR56, MT1G, and RASSF1 might be the potential methylation markers associated with acquired multidrug resistance of lung adenocarcinoma. PMID: 23902976
- Results describe MT1G promoter hypermethylation in hepatoblastoma and demonstrate that aberrant methylation is a frequent event in this malignancy. PMID: 20032811
- Loss of metallothionein 1G function due to hypermethylation of its promoter leads to athogenesis of papillary thyroid carcinoma PMID: 12640681
- Induction of the hMT1G promoter by VEGF and heavy metals occurs through the utilization of different transcription factors. PMID: 15735762
- Eight MT genes were up-regulated after treatment of T-ALL cells with 0.15 and 1.5 microg/mL of metal ores. Heavy metal binding activity. PMID: 15747776
- MT1G is hypermethylated in renal cell carcinoma. PMID: 18639284
- Using a panel of four genes (AHRR, p16INK4a, MT1G, and CLDN3) resulted in sensitivity and specificity of 50% and 68%, respectively and may have utility for early detection of esophageal squamous dysplasia and early ESCC. PMID: 19137073
- Promoter methylation and differential gene expression of five markers: COL1A2, NPM2, HSPB6, DDIT4L and MT1G were validated by sequencing of bisulfite-modified DNA and real-time reverse transcriptase PCR, respectively. PMID: 19491193
- p16INK4A, DAPK1, PTEN and MT1G genes were not frequently methylated in the stage I non-small cell lung cancer in China. PMID: 19506903
- MT1G acts as a tumor suppressor gene in hepatocellular carcinoma PMID: 19639168
顯示更多
收起更多
-
蛋白家族:Metallothionein superfamily, Type 1 family
-
數據庫鏈接:
Most popular with customers
-
-
YWHAB Recombinant Monoclonal Antibody
Applications: ELISA, WB, IHC, IF, FC
Species Reactivity: Human, Mouse, Rat
-
Phospho-YAP1 (S127) Recombinant Monoclonal Antibody
Applications: ELISA, WB, IHC
Species Reactivity: Human
-
-
-
-
-